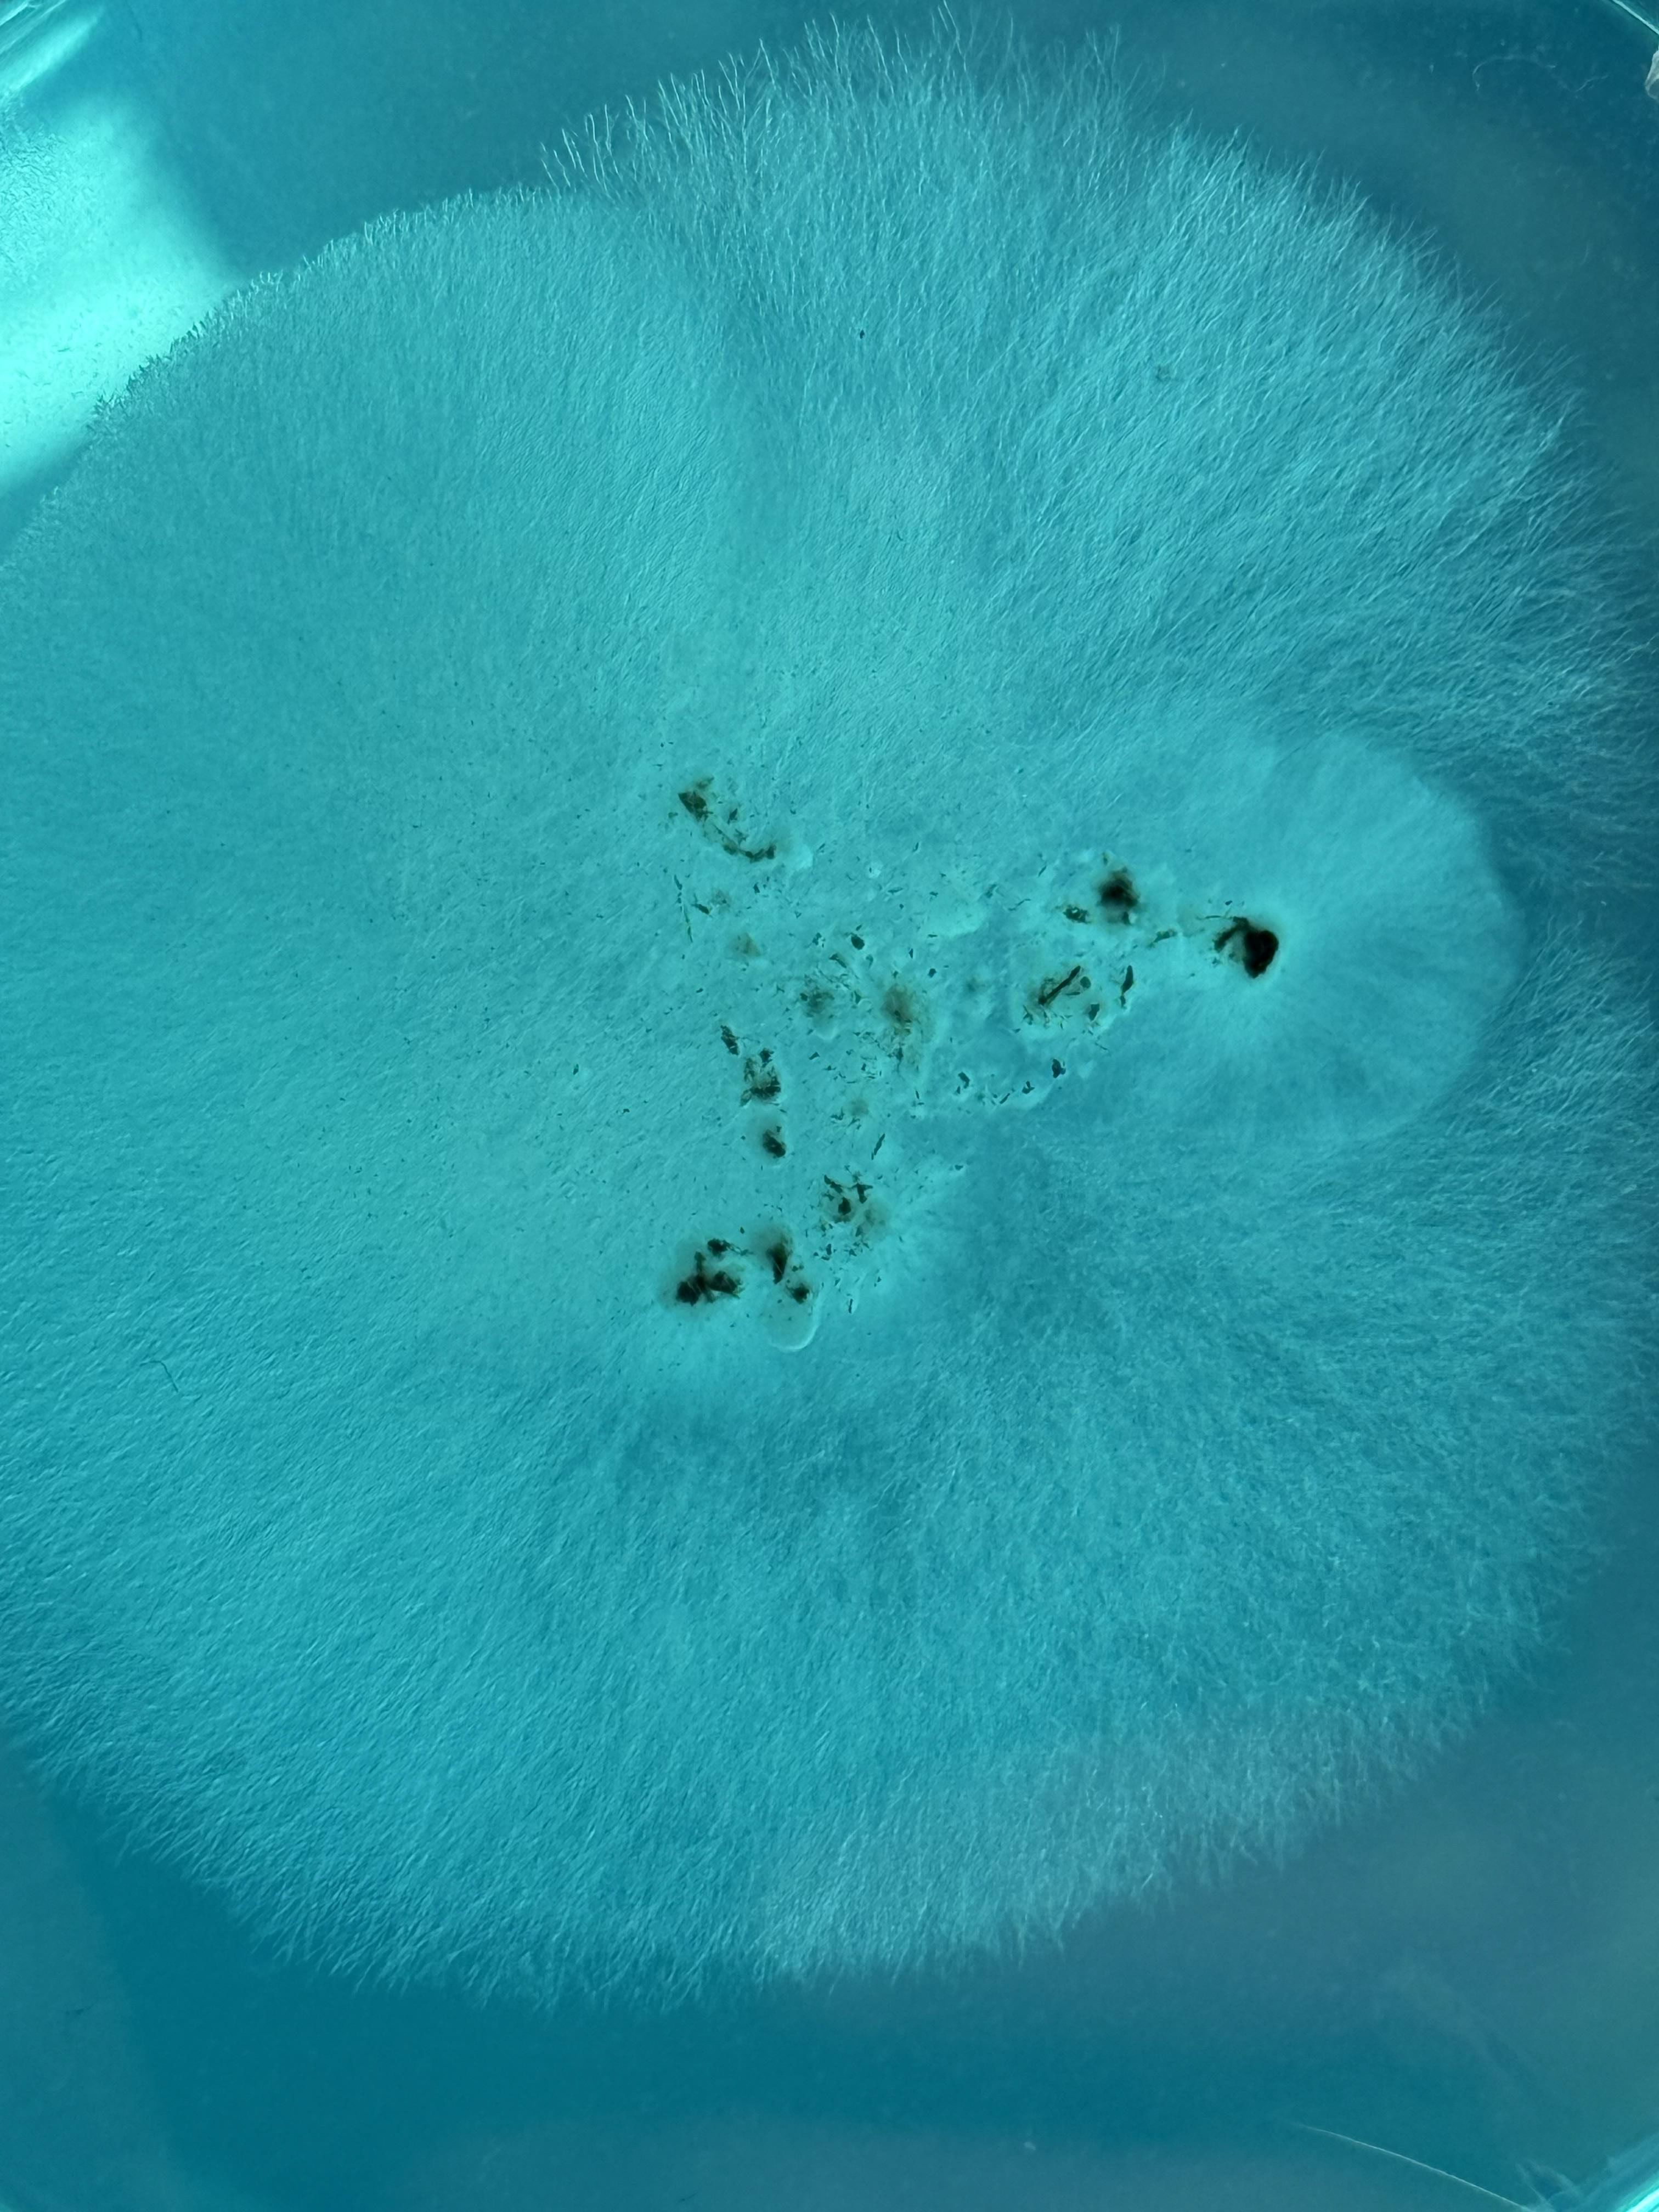
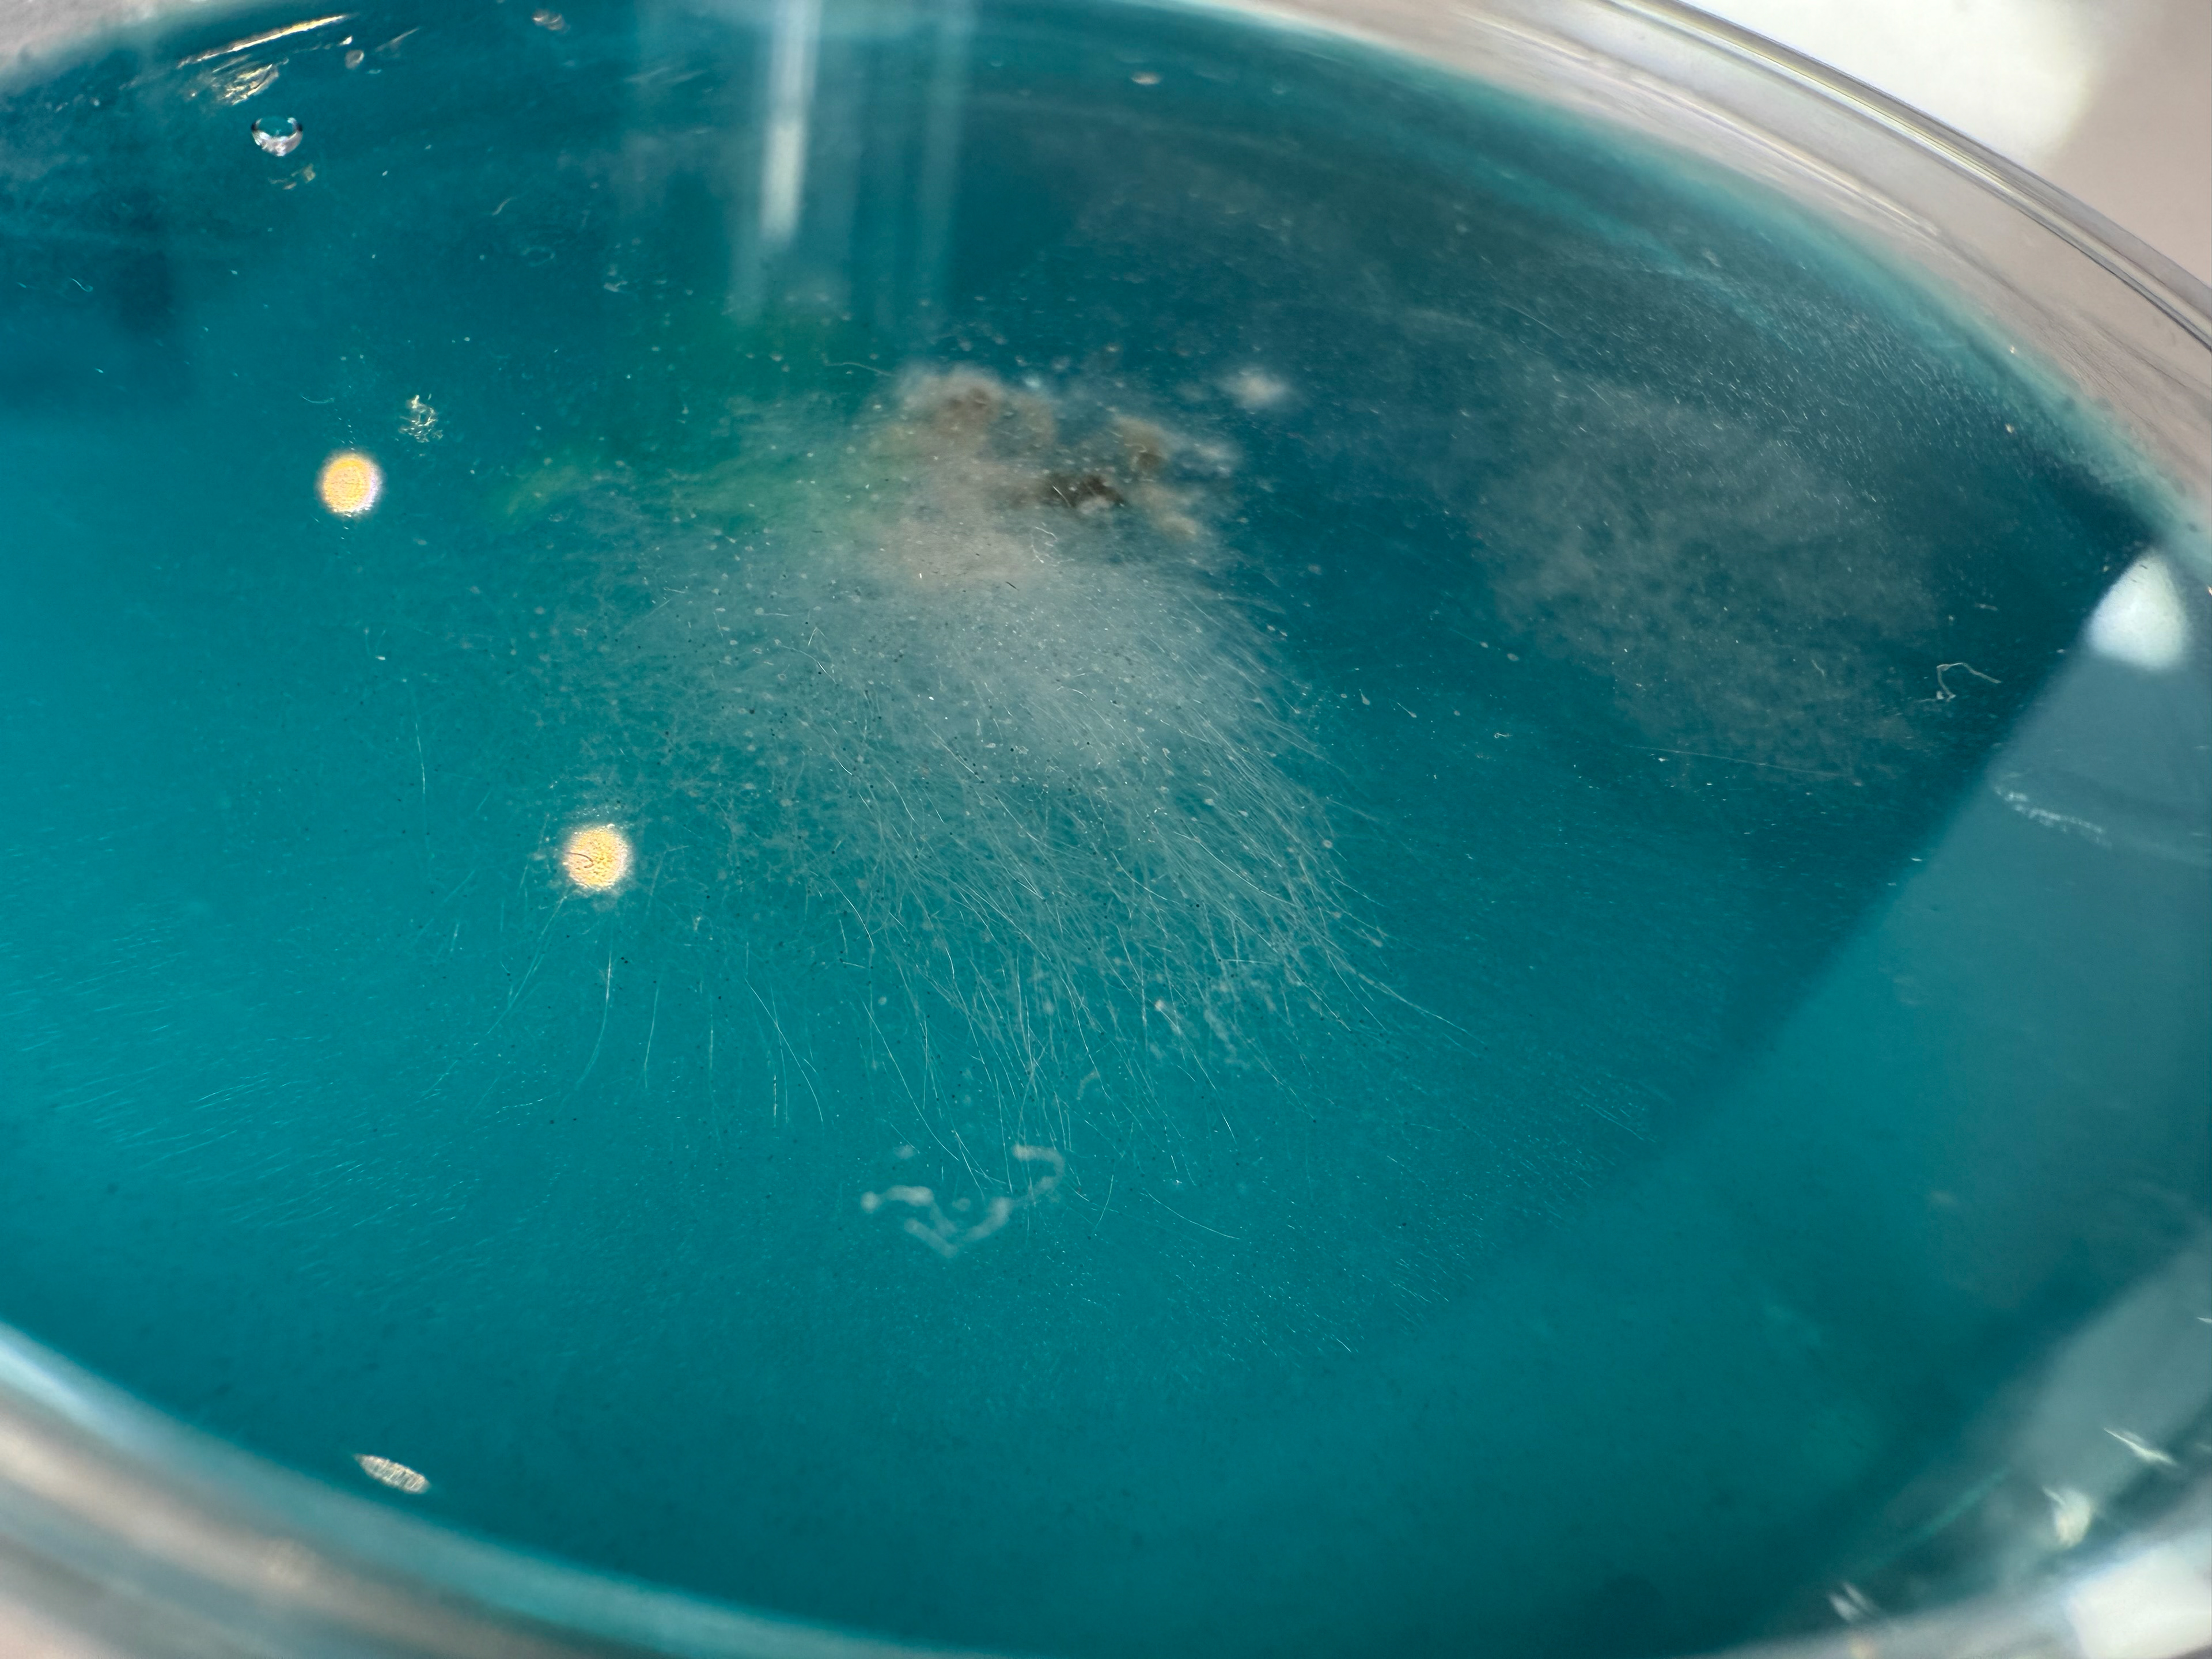

Motivated by a desire to capture the hidden life of peatland ecosystems, I have been using time-lapse photography to document the growth of mycelium, alongside microscopy to explore the microcosms of sphagnum, tardigrades, and other below-ground biodiversity. Samples from each site are collected using sterile charcoal swabs from soils and plants, cultivated on malt agar plates to encourage fungal growth while inhibiting bacteria. Each plate is carefully photographed, and while capturing growth on film presents ongoing technical challenges, the process continues to evolve, adding dynamic, immersive layers to my work that reveal life often invisible to the naked eye.

Mycelium Growth 1, Black Malt Extract Agar, (2025)
This short time-lapse was shot over four days, and shows the progressive growth of mycelium collected at Astley Moss on 29/04/2025.
The sample was collected using a sterile charcoal swab kit from amongst a sphagnum growth. This was placed on the agar plate at the site to reduce cross-contamination from another place.
This was my second attempt at time-lapse, so I am pleased that I managed to capture the growth; however, I am aware of some issues with the light and movement of the rig. Future experiments are required in a more controlled environment.






